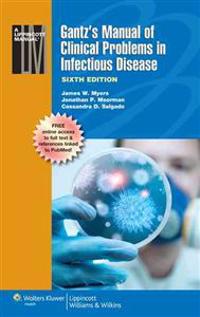

Murhahuone (Pocket)
avP.D. James
ISBN: 9789511254355 - UTGIVEN: 2012Herkkua perinteisen brittidekkarin ystäville!Komentaja Adam Dalgliesh käy yksityisessä Dupayne-museossa tutustumassa sen Murhahuone-näyttelyyn, joka esittelee sotien välisen ajan kuuluisia murhatapauksia. Silloin hän ei aavista, että joutuu pian palaamaan paikalle toisenlaisessa tilanteessa: [...]
Todistajan kuolema (Pocket)
avP.D. James
ISBN: 9789511257394 - UTGIVEN: 2011Itä-Englannin suoseudulla sijaitsevan rikostutkimuslaboratorion osastopäällikkö tohtori Lorrimer löydetään murhattuna työpaikaltaan. Asiaa selvittämään kutsutaan Scotland Yardista komentajaDalgliesh. Ankarana esimiehenä tunnettu Lorrimer ei elinaikanaan kerännyt ystäviä, ja lähes kai[...]
Kuoleman maku (Pocket)
avP.D. James
ISBN: 9789511263586 - UTGIVEN: 2012Brittidekkaria parhaimmillaan! Romaani on täynnä tiheää tunnelmaa, teräviä oivalluksia ja aavemaisia salaisuuksia.Sir Paul Berowne löydetään raa'asti surmattuna Lontoon Paddingtonissa sijaitsevasta kirkosta. TV-sarjasta ja runoilustaan tunnettu poliisipäällikkö Adam Dalgliesh ryhtyy ratk[...]
Murhaajan mieli (Pocket)
avP.D. James
ISBN: 9789511266686 - UTGIVEN: 2012Kuolevan naisen kirkaisu rikkoo psykiatrisen klinikan rauhan keskellä yötä, ja ylikomisario Dalgliesh kutsutaan murhatutkimuksiin suoraan kirjallisesta illanvietosta. Paikalle saavuttuaan Dalgliesh löytää klinikan työntekijän ruumiin retkottamassa pitkin kylmää kellarinlattiaa, sydän julm[...]
Kalman naamiot (Pocket)
avP.D. James
ISBN: 9789511269984 - UTGIVEN: 2012Kauniin ja terävän Cordelia Grayn etsivänura saa tervetulluta potkua, kun hänet palkataan räiskyvän näyttelijättären Claris Lislen seuralaiseksi ja suojelijaksi. Kuolemankauhua tihkuva romaani laajenee kohtalontarinaksi, jossa kirjailija kuljettaa taitavasti tapahtumia kolmella aikakaudella[...]
Viaton veri (Pocket)
avP.D. James
ISBN: 9789511271932 - UTGIVEN: 2012Varakkaiden adoptiovanhempien luona kasvanut Philippa Palfrey päättää kahdeksantoistavuotiaana ottaa selvää oikeista vanhemmistaan. Totuus on karumpi kuin hän olisi koskaan voinut kuvitella, ruusunpunaiset kuvitelmat murskautuvat yksi toisensa jälkeen. Vanhemmat ovat rikollisia ja äiti vapa[...]
Oikeus on sokea (Pocket)
avP.D. James
ISBN: 9789511272014 - UTGIVEN: 2013Kuka murhasi loistokkaan uran luoneen puolustusasianajajan Venetia Aldridgen? Rikostarkastaja Adam Dalgliesh tutkii kammottavaa tapahtumaketjua lontoolaisessa lakiasiaintoimistossa.Dalgliesh ryhmineen paljastaa mahdollisia motiiveja ja syyllisiä monelta taholta. Tutkimukset saavat uuden käänteen,[...]
Northanger Abbey (Pocket)
avJane Austen, P. D. (FRW) James, Jane Austen
ISBN: 9780099589297 - UTGIVEN: 2014-11This title comes with an introduction by P.D. James. The Vintage Classics Austen series is designed by the writer and illustrator Leanne Shapton and introduced by some of our finest contemporary writers and Austen fans: Alexander McCall Smith, Lynne Truss, Amanda Vickery, Francesca Segal, P.D. James[...]
Aerial Photography and Image Interpretation, 3rd Edition (Häftad)
avDavid P. Paine, James D. Kiser
ISBN: 9780470879382 - UTGIVEN: 2012-03-31This new edition brings a respected book up to date with current technology and practice, additional coverage of the camera equipment used, and more discussion of digital photography and color theory. It focuses on aerial photography and image interpretation, allowing for a much more thorough presen[...]
Devices and Desires (Pocket)
avJames, P D
ISBN: 9780571248889 - UTGIVEN: 2010-04-01Commander Adam Dalgliesh visits Larksoken, a community in the shadow of a nuclear power station, engaged in tying up his aunt's estate. A serial killer known as the Whistler is terrorising the neighbourhood and Dalgliesh is drawn into the lives of the headlanders when it quickly becomes apparent tha[...]
Self-Assessment in Head and Neck Surgery and Oncology (Pocket)
avM.D. O'neill James Paul, Jatin P., M.D., Ph.D. Shah
ISBN: 9780323260039 - UTGIVEN: 2014-06-01Stroke (Inbunden)
avJ. P. Mohr, Wolf, Philip A., M.D., Grotta, James C., M.D., Michael A. Moskowitz, Mayberg, Marc R., M.D.
ISBN: 9781416054788 - UTGIVEN: 2011-03-31Molecular Biology of the Gene (Övrigt)
avJames D. Watson, Tania A. Baker, Stephen P. Bell
ISBN: 9780321507815 - UTGIVEN: 07-DecThe classic textbook in molecular biology, updated with new chapters, new information, and new media.
Completely up-to-date with the latest research advances, the Sixth Edition of James D. Watsonâs classic text, Molecular Biology of the Gene retains the distinctive character of earli[...]Molecular Biology of the Gene (Inbunden)
avJames D. Watson, Tania A. Baker, Stephen P. Bell
ISBN: 9780321762436 - UTGIVEN: 2013-02Now completely up-to-date with the latest research advances, the Seventh Edition of James D. Watson's classic book, Molecular Biology of the Gene retains the distinctive character of earlier editions that has made it the most widely used book in molecular biology. Twenty-two concise chapters, co-aut[...]
Molecular Biology of the Gene (Häftad)
avJames D. Watson, Tania A. Baker, Stephen P. Bell
ISBN: 9780321827265 - UTGIVEN: 2012-01Molecular Biology of the Gene (Häftad)
avJames D. Watson, Tania A. Baker, Stephen P. Bell
ISBN: 9780321905376 - UTGIVEN: 2013-02This edition features the exact same content as the traditional text in a convenient, three-hole-punched, loose-leaf version. Books a la Carte also offer a great value for your students-this format costs 35% less than a new textbook. Now completely up-to-date with the latest research advances, the S[...]
Molecular Biology of the Gene with Access Code (Häftad)
avJames D. Watson, Tania A. Baker, Stephen P. Bell
ISBN: 9780321906441 - UTGIVEN: 2013-02Books a la Carte are unbound, three-hole-punch versions of the textbook. This lower cost option is easy to transport and comes with same access code or media that would be packaged with the bound book. Now completely up-to-date with the latest research advances, the Seventh Edition of James D. Watso[...]
The Yeast Connection: A Medical Breakthrough (Häftad)
avWilliam G., M.D. Crook, James H. Brodsky, Cynthia P. Crook
ISBN: 9780394747002 - UTGIVEN: 198609An in-depth guide to those health problems in people of all ages and sexes that can be traced to sensitivity to the yeast germ candida albicans.[...]
High-Speed Networking: A Systematic Approach to High-Bandwidth Low-Latency (Häftad)
avJames P. G. Sterbenz, Joseph D. Touch
ISBN: 9780471330363 - UTGIVEN: 2001-05-31"Building networks with high performance demanded by today's applications requires a complete understanding of the basic principles and latest techniques. This book is the definitive guide to both."-Lyman Chapin
High-speed networking is the essential enabler of modern sophisticated distributed [...]Atlas of Histology (Pocket)
avDongmei Cui, John P. Naftel, Jonathan D. Fratkin, William Daley, James C. Lynch, Duane E. Haines
ISBN: 9780781797597 - UTGIVEN: 2010-09-01Atlas of Histology: With Functional and Clinical Correlations is a brand-new atlas that provides students a practical and useful source of fundamental information concerning basic histology. Using a unique one-page layout, the book presents a complete visual impression in an integrated style: light [...]
World History (Pocket)
avJiu-hwa Lo Upshur, Janice J. Terry, James P. Holoka, George H. Cassar, Richard D. Goff
ISBN: 9781111345136 - UTGIVEN: 2011-01-20Developed to meet the demand for a low-cost, high-quality history book, CENGAGE ADVANTAGE BOOKS: WORLD HISTORY, Fifth Edition, offers readers the engaging WORLD HISTORY text in a compact, affordable format. WORLD HISTORY is a global text that examines world civilizations in a comparative way. Learn [...]
World History (Pocket)
avJiu-hwa Lo Upshur, Janice J. Terry, James P. Holoka, George H. Cassar, Richard D. Goff
ISBN: 9781111345167 - UTGIVEN: 2011-01-20Developed to meet the demand for a low-cost, high-quality history book, CENGAGE ADVANTAGE BOOKS: WORLD HISTORY, Fifth Edition, offers readers the engaging WORLD HISTORY text in a compact, affordable format. WORLD HISTORY is a global text that examines world civilizations in a comparative way. Learn [...]
Open-end Problems: The Future Chemcial Engineering Education Approach (Häftad)
avRita D'aquino, Louis Theodore, James P. Abulencia
ISBN: 9781118946046 - UTGIVEN: 2015-01-31Gantz's Manual of Clinical Problems in Infectious Disease (Häftad)
avJames W. Myers, Jonathan P. Moorman, Cassandra D. Salgado
ISBN: 9781451116977 - UTGIVEN: 201211"Gantz's Manual of Clinical Problems in Infectious Disease Sixth Edition" - Since publication of the First Edition in 1979, much has changed in the way we view, diagnose, and treat infectious diseases. The Sixth Edition of this respected reference focuses on challenging clinical situations faced by [...]
Fundamentals of Refractory Technology: Proceedings of the Lecture Series pr (Häftad)
avEditor:James P. Bennett, Editor:Jeffery D. Smith
ISBN: 9781574981339 - UTGIVEN: 2001-05-31